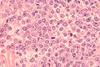
shutterstock_1024292422

All prednisone articles
-
News
NewsNon-chemotherapy lymphoma treatment may provide durable remission
Fifty four percent of evaluable patients with DLBCL attained a substantial tumour reduction with the five-drug regimen, trial data shows.
-
 News
NewsMHRA approves ‘safer’ medicine alternative for rare disease
A new drug has been approved in the UK as a safer alternative to corticosteroids to treat Duchenne muscular dystrophy (DMD).



